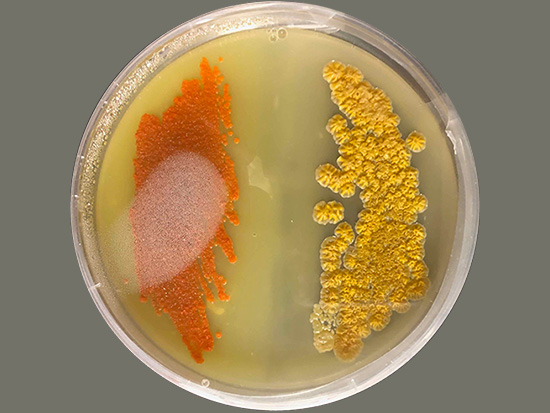
SYNAPT G2Si

Equipment
Mass Spectrometers
 |
 |
Waters XevoMRTUPLC-ESI-multi reflectance-qTOF |
Waters SYNAPT G2SiUPLC-ESI-IMS-qTOF |
 |
 |
Waters RDAUPLC-ESI-TOF |
Waters SQD2HPLC-ESI-single quad |
 |
 |
Agilent 6130HPLC-ESI-single-quad Walk-up LRMS system |
Agilent HPLCsOur farm of HPLC purification systems |
Laboratory
 |
|
Microbial Extract LibraryPart of our library of prefractionated microbial extracts for natural products discovery |
Petri plateWe do microbiology too! Isolation plates from our growing environmental isolate collection |
Center for High-Throughput Chemical Biology (HTCB)
 |
 |
HTCB PlatformWe are fortunate to have access to the automation facilities in SFU's Center for High-Throughput Chemical Biology |
HTCB AutomationThe HTCB includes a large suite of robotic liquid handling instruments for projects at the interface of chemistry and biology |

